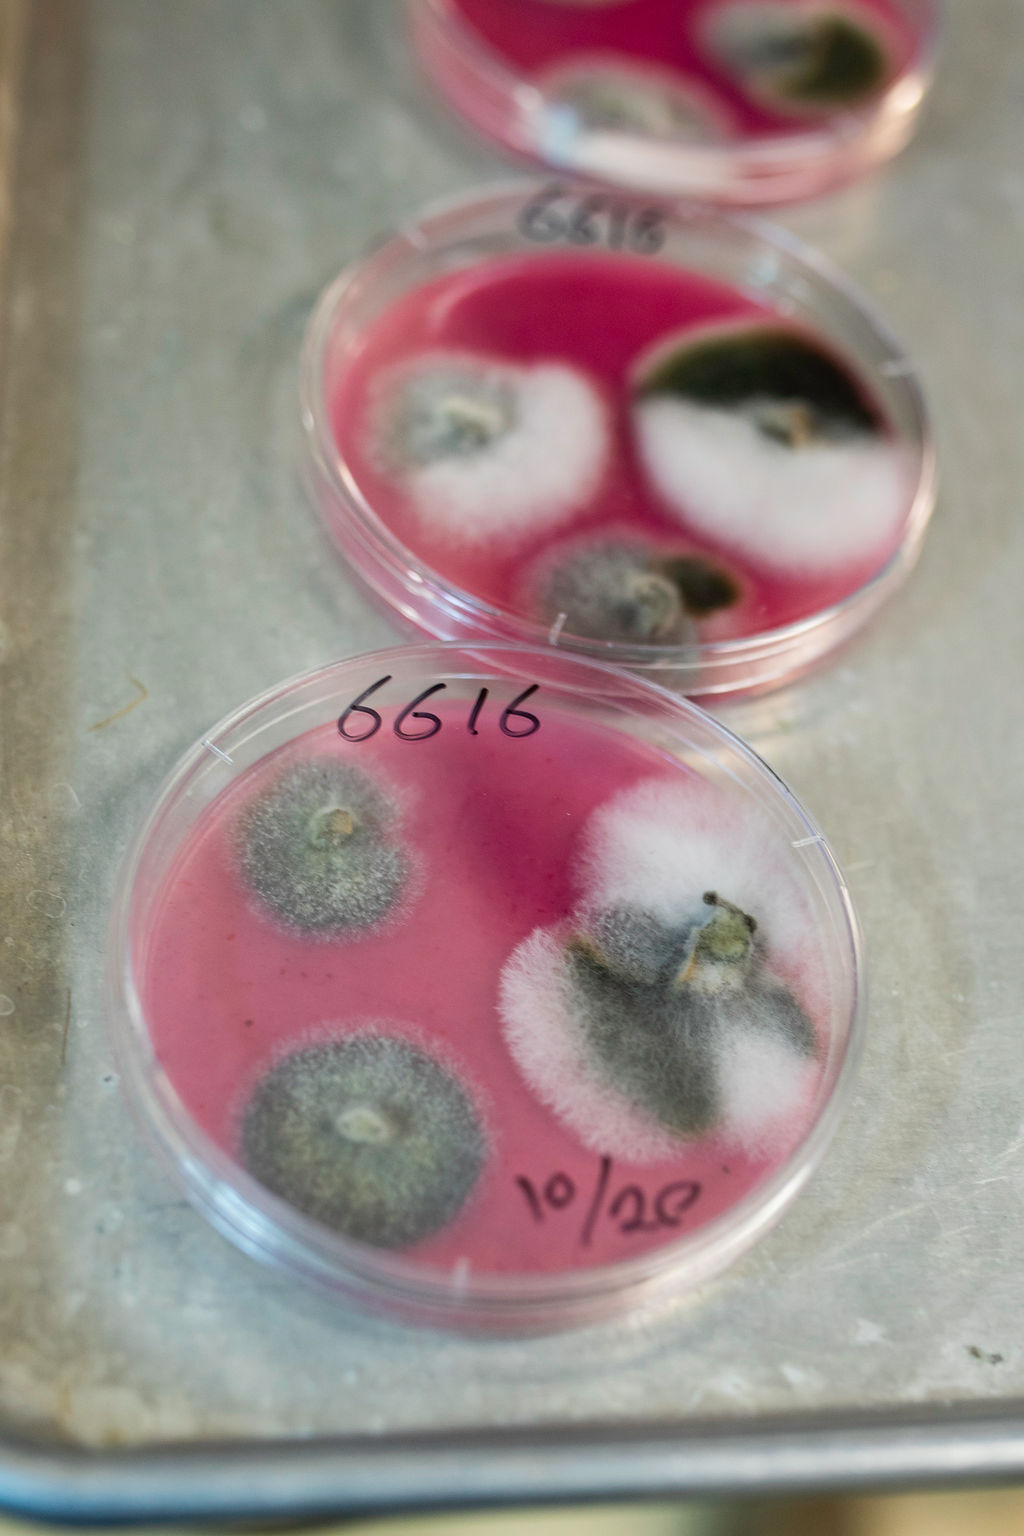

Canola
One of the most widely grown crops in Canada, canola plants produce beautiful small yellow flowers which develop into pods, resembling pea pods. Each pod contains tiny black seeds, made up of about 45% oil. Once harvested, canola seeds are crushed to release the oil contained within the seed.
Canola grown in Canada belongs to the Brassica napus B. rapa or B. juncea species which belong to a larger mustard family (Brassicaceae). Cabbage, broccoli and cauliflower are also part of this same botanical family.

Production Resources
SaskOilseeds works strategically with the canola network to provide Saskatchewan growers with the resources and tools needed to optimize canola production and profitability on their individual farms.
- Canola Encyclopedia – your complete guide to growing canola in Canada.
- Canola Digest – the official magazine of Canada’s canola growers.
- Canola Watch – canola research-focused weekly e-newsletter.
Click the button below to visit our Resource Library for so much more…

Disease Testing Program
SaskOilseeds in partnership with the Saskatchewan Ministry of Agriculture, are ensuring farmers have the tools they need to detect the most devastating canola diseases. Our current disease monitoring program includes clubroot, blackleg and verticillium stripe testing.
- Details below provide information about how to participate.
- Deadline to submit samples: October 31, 2025

Marketing Resources
Canadian farmers need an open and competitive marketing environment to prosper.
This includes transparent and accountable government institutions that meet farmers’ needs, balanced grain marketing contracts, and timely pricing and marketing data.
- KnowYourGrade.ca – provides info about representative sampling, dockage, grading, and available producer protections.
Canadian farmers work hard to produce crops to the highest standard.
The quality and reputation of Canadian canola, cereals and pulses is amongst the best in the world. Your on-farm practices DO make a difference. To avoid unacceptable residue levels in grain, keep it clean – use only acceptable crop protection products and use them correctly.
- KeepItClean.ca – provides timely updates about potential market risks and resources to grow market-ready crops that meet the standards of domestic and export customers.

Registered Buyers
Are you a buyer of canola grown in Saskatchewan? Do you know your buyer responsibilities? Under the Oilseeds Development Plan Regulations, any person who buys canola produced in Saskatchewan must:
- Register with SaskOilseeds each crop year (August 1 to the following July 31)
- Deduct a levy of 75 cents per metric tonne from any payment made to canola producers
- Report to SaskOilseeds, by the 20th of each month, the total volume of canola acquired from each producer for the previous month. The following information is required:
- The amount of canola purchased from the producer;
- The amount of levy being paid on behalf of the producer;
- The name and address of the producer.
- Remit the levy to SaskOilseeds within 55 days from the end of the month within which the levy was collected.

